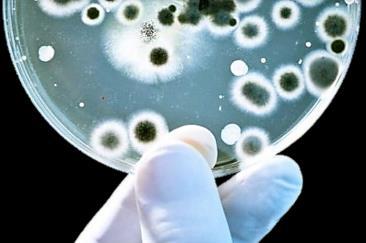

Ingegneria dei sistemi adesivi







La Società Bond S.r.l. è composta da professionisti qualificati con almeno 20 anni d’esperienza specifica in soluzioni industriali di tenuta, mediante adesivi o collanti. La Società nasce nel 2009 dall’esigenza di flessibilità e dalla richiesta di servizi speciali del mercato moderno. In un momento di rapido cambiamento dell’industria internazionale è obbiettivo comune essere altrettanto rapidi, con magazzini ben forniti e particolare attenzione alla fase di consulenza e valutazione della soluzione da trovare. All’interno di questa nuova ottica il cliente è parte della nostra squadra e partecipa integralmente al grado di soddisfazione richiesto dagli obbiettivi aziendali. La Società Bond dispone di un servizio d’ingegneria competente e sensibile alle esigenze della clientela, con strumenti all’avanguardia, per poter rispondere nel minor tempo possibile alle richieste più complesse. Localizzata geograficamente nel cuore dell’Emilia Romagna è in grado di servire l’intero territorio nazionale con tempestività e competenza. Il know-how dei professionisti fondatori hanno permesso di creare una linea di prodotti a marchio proprio che vanta numerose omologazioni in aziende di riferimento internazionali.







È assodato che un incollaggio di qualità e ad alte prestazioni, si ottiene, allorché l’obiettivo viene perseguito a tutti i livelli del processo di progetto e produzione. È fondamentale, che il progetto del manufatto venga elaborato avendo presente, fin dall’inizio, che il sistema di fissaggio dei componenti sarà un incollaggio e non che si proceda ad incollare componenti pensati e progettati per un fissaggio meccanico.

Molti manufatti prodotti nel mondo sono costituiti da diversi pezzi o componenti

Dilatazioni termiche



Nasce quindi la necessita’ di unire questi componenti tra di loro


Sempre piu’ frequentementesi ricorre alle giunzioni mediante incollaggio


Questa tecnica di giunzione e’ ben consolidata e capace di sostituire o integrare i metodi di fissaggio meccanici, comportando diversi vantaggi




















le strutture incollate, sono piu’ rigide













La maggiore rigidezza dei giunti incollati, e’ dovuta alla caratteristica di continuita’ dell’incollaggio stesso, risultato ottenuto con minor peso.










l’incollaggio e’ continuo


















l’incollaggio può essere usato in assemblaggi complessi





















Questo comporta una più uniforme distribuzione delle tensioni sull’area incollata Le concentrazioni di tensioni locali presenti nelle saldature punti nei giunti fissaggio meccanico, sono evitate Le strutture incollate possono godere di una vita operativa più lunga.

















Tra queste strutture si possono annoverare pannelli nido d’ape multistrato, dove i fissaggi mediante incollaggi, garantiscono l’integrità strutturale del manufatto



























l’incollaggio può unire materiali differenti













l’incollaggio riduce le concentrazioni di tensione








































La struttura incollata e’ più sicura, perché in virtù delle minori concentrazioni di tensioni, fenomeni di rottura per fatica sono meno frequenti. Infatti una cricca di fatica si propaga meno rapidamente in una struttura incollata rispetto ad una struttura rivettata perché bordi dell’incollaggio funzionano da argine alla propagazione della cricca.










l’incollaggio può funzionare da smorzatore














L’incollaggio ha buone proprietà di smorzamento. Questa capacità può risultare molto utile nella riduzione del rumore delle vibrazioni.














l’incollaggio può unire materiali sensibili al calore
















fissaggio mediante incollaggio e’ particolarmente indicato per unire materiali sensibili al calore soggetti quindi distorsioni modifiche delle proprietà, cosa che succede per le brasature le saldature.

L’incollaggio può isolare elettricamente

























Mediante incollaggio si possono facilmente unire materiali che possono avere differenti composizione, moduli elastici, coefficienti di espansione termica, spessori.






















può semplificare le procedure di assemblaggio sostituendo diverse giunzioni meccaniche con un semplice adesivo, o può consentire la giunzione di parecchi componenti con una sola operazione di fissaggio. noltre può essere usato in combinazione con altri sistemi di fissaggio, quali le rivettature le saldature punti, per migliorare le prestazioni della struttura completa.
















































le strutture incollate presentano un aspetto migliore










L’incollaggio garantisce un aspetto piu’ regolare ai componenti. Non ci sono protuberanze, come nelle bullonature rivettature ne’ tracce come nelle saldature a punti. Nell’ambito dei progetti spaziali, risponde al soddisfacimento dei requisiti di sicurezza



























l’incollaggio può ridurre fenomeni corrosivi














Lo stato continuo di adesivo forma una specie di guarnizione. giunti quindi sono conseguentemente tenuta e meno soggetti corrosione.





Lo strato di adesivo può costituire un isolamento elettrico tra le superfici unite.

Comportamento e idoneità dei materiali

Velocità relativa di polimerizzazione
Riempimento dei vuoti
Resistenza a taglio da trazione
Resistenza alla pelatura
Resistenza all’impatto
Resistenza alle alte temperature
Anaerobici (per contatti metallo/metallo, ad es. frenafiletti)
Epossidici (nella forma resina epossidica + indurente)
Acrilici reattivi (bicomponenti)
Poliuretanici (nella forma mono o bicomponente per plastiche fibro rinforzate)
media bassa Elevata Bassa
Cianoacrilati (rinforzati con elastomeri per impiego strutturale)
Poliuretanici reattivi a caldo
Molto bassa Bassa Alta
Molto alta
Molto bassa Bassa Alta Alta
Molto elevata
Bassa per un fissaggio rapido
Bassa Alta
Bassa Alta
Resistenza ai fluidi Eccellente Eccellente Buona Discreta Discreta Discreta
Costo Elevato Basso Medio Medio
Molto elevato Elevato














































Principali sostanze e rispettivo coefficiente di dissipazione termica espresso in diverse unità di misura

La conducibilità è funzione della temperatura ma nell a maggioranza dei casi tale variazione è trascurabile.
- Materiali con elevata conducibilità = Conduttori
- Materiali con bassa conducibilità = Isolanti


Nastri mono adesivi in POLYIMMIDE per mascherature ad alta temperatura Creati la protezione dei contatti nei processi saldatura a onda Adesivo Siliconico Fornibili anche con liner e fustellati a disegno


Nastri mono adesivi in poliestere per operazioni di mascheratura alle alte temperature. Adesivi siliconici. Fornibili





Nastri mono adesivi in fibra di vetro per fissaggi e protezioni ad alta temperatura
Adesivo Siliconico. Fornibili anche con liner e fustellato a disegno Fornibili anche con liner e fustellati a disegno.




Nastri mono adesivi autolubrificanti a base di Vetro-PTFE , PTFE estruso o sfogliato. Applicato su barre saldanti e in tutti quei processi in cui serve resistenza termica e basso coefficiente d’attrito Adesivi Siliconici Fornibili anche con liner e fustellati

BND8810
Termo-conduttivi
Nastri bi-adesivi termo-conduttivi Creati per dissipare il calore in eccesso di componenti elettronici e contemporaneamente fissarli meccanicamente. Fornibili anche fustellati a disegno Fino a 0,7 Wm°K

BND425 – BND431 Alluminio
Nastri mono adesivi in alluminio per operazioni di mascheratura alle alte temperature, cromo tecnica e fissaggio spirali del freddo Adesivi acrilici e siliconici Fornibili anche con liner e




Adesivi mono e bi-componente per alte temperature







Vetro , metalli, marmo, pietre termoplastici


Fotovoltaico, elettronica, aerospaziale, motori






COSTRUTTORI CMACCHINE
•FRIGORIFERI
•ABBATTITORI
•CELLE REFRIGERATE




FISSAGGIO BIADESIVO FINO A -55°C





•LABORATORI
•AEROSPAZIALE

FISSAGGIO STRUTTURALE ADESIVO FINO A temperature criogeniche


•ELETTRONICA
•AUTOMOTIVE
•AERTOSPACE


MATERIALI ADESIVI RESISTENTIO FINO A -55°C


PRODOTTI PER LA SIGILLATURA E CONDUZIONE DEL FREDDO




• BANCHI FRIGO
• ACCIAI E OVERLAPPING
• CLIMATIZZAZIONE












Il mondo delle tecnologie adesive è costretto a misurarsi con una gamma di materiali tendenti all’infinito. L’evoluzione tecnologica e le crescenti variabili coinvolte nei processi produttivi (additivi, stabilizzanti, pigmenti, cariche, distaccanti) sono una piccola parte delle variabili che condizionano la buona riuscita di un processo d’incollaggio. A questo proposito può essere di grande aiuto nella fase preliminare, testare le superfici con una semplice gocciolina d’acqua. Tale esperienza consentirà di verificare in maniera semplice e veloce se esistono possibilità reali di ottenere una buona tenuta del sistema. Esistono comunque buone possibilità anche su materiali definiti critici o LSE (low surface energy) grazie a linee di prodotti dedicati e a preparatori superficiali.
Nastri e colle per materie plastiche difficili ( LSE - LOW SURFACE ENERGY)




E’ importane notare che materiali ad alta energia superficiale posseggono anche elevata rapidità di ossidazione, bassa resistenza alla corrosione:
Proprietà Metalli Polimeri
Energia superficiale alta bassa
Velocità di ossidazione alta bassa
Adesione iniziale alta bassa
Resistenza all’invecchiamento bassa alta
Funzione del primer
Protegge la superficie
Protegge la superficie Ne aumenta la resistenza alla corrosione Ne aumenta l’adesione iniziale

BND 0108
Adesivo bicomponente
strutturale rapido per polietilene e polipropilene.
Rapporto10:1.


Poliuretano (PU)
Politetrafluoretilene (PTFE)
Polistirene (PS)
Polipropilene (PP)
poli-fenilene sulfide (PPS)
poli-metil-pentene (PMP)
poli-butilene tereftalato (PBT)
poli-perfluoro-alcoxietilene (PFA)
olietilene a bassa densità (LDPE)
Etilen tetrafluoretilene (ETFE)
Resine Acetaliche





Forza di adesione (Kg/cm²) senza primer
Forza di adesione (Kg/cm²) con primer

Biadesivi LSE
Nastri biadesivi sottili per la bassa energia superficiale















La società Bond S.r.l. , dispone del know-how e dei prodotti per:

A)valutare e risolvere problemi di fissaggio o protezione, mediante materiale adesivo rispondente alle più severe normative di resistenza alla fiamma, di opacità dei fumi, RoSH compliant, Halogen free, conformi alla direttiva europea 2000/53/EC per “End of Vehicle Life” (ELV) riciclaggio (elettronica – auto motive – macchine automatiche - elettrodomesticiilluminotecnica)
• Nastri mono e biadesivi , in rotolo o fustellati Flame retardant (FR) – RoSH compliant – Halogen free – ED2000/53/EC (ELV)
• Colle e sigillanti UL94 V0 - RoSH compliant – Halogen free – ED2000/53/EC (ELV)
Resistenza alla fiamma UL 94
Con il metodo UL (underwriters laboratories) si ottengono informazioni sulla resistenza alla fiamma del materiale da analizzare. La prova viene realizzata con un'apparecchiatura: un’estremità del provino, supportato verticalmente, viene sottoposta ad una fiamma attraverso un Bunsen, alta 20 mm, che viene applicata due volte per 10 secondi
In base a:
• Comportamentodel materiale
• Tempi di combustione del provino
• Eventuale caduta di gocce di materiale incandescente con accensione del sottostante strato di cotone

I materiali vengono classificati secondo le seguenti classi:
• V-0: il tempo di combustione dopo ogni applicazione della fiamma non supera i 10 secondi e non si ha sgocciolamento di particelle infiammate che incendiano il cotone idrofilo posto sotto il provino
• V-1: il tempo di combustione dopo ogni applicazione della fiamma non supera i 30 secondi e non si ha sgocciolamento di particelle infiammate che incendiano il cotone idrofilo posto sotto il provino
• V-2: il tempo di combustione dopo ogni applicazione della fiamma non supera i 30 secondi ed è permesso che alcune gocce infiammate incendino il cotone idrofilo posto sotto il provino
• HB: quando non è classificabile come sopra e nella prova con provino orizzontale si hanno velocità di bruciatura <38mm/min per spessori >3mm e <76mm/min per spessori <3mm.
Resistenza alla fiamma. Comportamento al fuoco EN50265; IEC 60332-1
La fiamma di un becco Bunsen, viene applicata ad uno spezzone di cavo posto in posizione verticale per un tempo proporzionale alla sua massa. La prova si intende superata se allo spegnimento del Bunsen il cavo cessa di bruciare e le tracce della combustione non si estendono oltre un certo limite.
Non propagazione d’incendio. EN 50266; IEC 60332-3
La combustione dei materiali non metallici non si deve propagare oltre un determinato limite. In una struttura standard la prova di non propagazione dell’incendio avviene in una camera verticale di 1 m x 2 m x 4 m. La sorgente di calore è costituita da un bruciatore di propano a nastro con una potenza nominale di 73 7±1 68 MJ/h il ricambio d’aria all’interno della camera deve essere d’aria pari a 5000 ± 500 l/min, La temperatura viene mantenuta costante a 750°C A seconda del volume di materiale non metallico combustibile) per metro lineare, avremmo una classificazione nelle seguenti categorie: A F/R, A, B, C, D. Il materiale deve auto-estinguersi una volta eliminata la fonte della fiamma, ed inoltre il fuoco non si deve propagare per più di 2,5mt dal punto di contatto del bruciatore.


Emissione dei fumi. Standard di riferimento: EN 50268; IEC 61034
Con questo test si valuta la densità dei fumi emessi dal materiale non metallico che brucia. Il dato di riferimento si ottiene valutando



la quantità di luce che penetra attraverso i fumi. Il campione viene incendiato, con una miscela di alcool, all’interno di una camera specifica (di norma cubica, con un lato di 3 metri). Da un lato è posta una fotocamera e dall’altro una fonte di luce . Il fumo che si sviluppa viene distribuito all’interno della stanza da un ventilatore. A questo punto vengono fatti dei test di misurazione del livello di luce visibile. In mancanza di prescrizioni è raccomandabile adottare un valore minimo di trasmittanza pari a :
HL 1 = -
HL 2 and 3 = 60 %
HL 4 = 70 %
La direttiva RoHS (Restrizione dell'uso di determinate sostanze pericolose) limita l'utilizzo di sei sostanze:
□ Piombo (Pb)
□ Mercurio (Hg)
□ Cromo esavalente (Cr (VI))
□ Cadmio (Cd)
□ Ritardanti di fiammabifenili polibromurati (PBB)
□ Ritardanti di fiamma eteri di difenile polibromurati (PBDE)
La direttiva 2002/96/CE, anche nota come WEEE, è volta a prevenire e limitare il flusso di rifiuti di apparecchiature destinati alle discariche, attraverso politiche di riuso e riciclaggio degli apparecchi e dei loro componenti. La direttiva applica il concetto della Responsabilità estesa del produttore (chi inquina paga). Difatti i produttori avranno l'obbligo di provvedere al finanziamento delle operazioni di raccolta, stoccaggio, trasporto, recupero, riciclaggio e corretto smaltimento delle proprie apparecchiature una volta giunte a fine vita. Tale responsabilità finanziaria sarà di tipo individuale per i prodotti immessi sul mercato dopo l'entrata in vigore della direttiva (13 agosto 2005) e collettiva per i prodotti immessi prima di tale data





Gli Alogeni sono 5 elementi non metallici presenti nel gruppo 7 della Tavola degli Elementi. Il termine"alogeno" significa "formato da sali" e composti contenenti alogeni sono chiamati "sali".
Gli Alogeni sono:
• Fluoro
• Cloro
• Bromo
• Iodio
• Astatine
In generale con il termine “halogen-free” si intende un prodotto con non contiene nessun componente derivato da questi elementi. Molte persone nell’industria elettrica ed elettronica definiscono “halogen-free” come l’organizzazione IPC (Association Connecting Electronics Industries) specifica nei suoi bollettini “Elettronica e prodotti elettronici” sono da considerare ‘halogen-free’ se siano stati assemblati senza intenzionalmente usare questi elementi nelle materie prime e, questi elementi, non sono presenti intenzionalmente nel prodotto finale.
Terminologia comune per indicare prodotti “Halogen-Free”:
• Halogen Free
• Zero Halogen
• No Halogen
• 0H
• ZH


La Direttiva 2000/53/CE è relativa allo smaltimento dei rifiuti derivanti dalla rottamazione dei veicoli (End Life of Vehicle).Obiettivo della direttiva è la protezione dell'ambiente, eliminando o riducendo, per la costruzione dei veicoli, l'utilizzo di sostanze riconosciute come pericolose (Piombo, Cadmio, Mercurio, Cromo esavalente-CrVI) e promuovendo la raccolta, il riutilizzo ed il riciclaggio dei materiali provenienti dalla rottamazione a fine vita veicolo.


• Espositori
• Teche
• Mosaici



• Lavorazioni materie plastiche
• Resinatori
• Dooming
• Coating

Biadesivi in nastro semistrutturali
• Assemblaggi
• Espositori
• Automotive

BI-COMPONENTI
Poliuretaniche
Epossidiche
Siliconiche
Ciano acrilici
MONOCOMPONENTI
Epossidiche
Siliconiche
Ciano acrilici



• Coating
• Colata


• Automotive
• Cucine
• Rinforzi Ω

Trattamenti chimici

Elettro erosivi

strutturali
Mono adesivi protezione mascheratura
componente strutturali
• Automotive
• Aerospace
• Costruttori macchine automatiche
• Lavelli – cappe INOX










Bi adesivi semistrutturali

• Tavoli Armadi
• Industria alimentare

• Cappe aspirazione
• Lavelli inox


•Laminazione con taglio a passo
•FULL CUT
•HALF CUT
•ROLL TO ROLL

500X1200
•SHEET TO SHEET


•TAGLIO A LAMA OSCILLANTE PROFONDITA’ MAX 100MM. PIANO 1500X2500




RISOLUZIONE FOTOGRAFICA
•FINO A 2MM. RILIEVO
•ADESIVO PROGETTATO




• CROMATURA
• GALVANICA
• PLASMA

MONO ADESIVI
MONO ADESIVI
POLIPROPILENE POLIESTERE

• AUTOMOTIVE


MONO ADESIVI
MONO ADESIVI TECNICI
• DISPLAY
• CRUSCOTTI
• STRUMENTAZIONE
• APPARECCHI
MEDICALI



• ELETTRONICA
• SALDATURA





• SEGNALETICA
ORIZZONTALE
SICUREZZA 81/ 2008
• INDUSTRIA


MONO ADESIVI COLORATI
MONO ADESIVI TATTICI
• EFFRAZIONE


MONO ADESIVI
RIFRANGENTI
OMOLOGATI
ECE ONU 104
AUTOMOTIVE
• TRASPORTI
ROBOTICA

MONO ADESIVI VIRANTI
• STERILIZZATORI
• VAPORE
• OSSIDO DI ETILENE



• ARREDAMENTO
• MACCHINE
AUTOMATICHE
• ELETTRONICA
• ALIMENTARE
• ARREDAMENTO
• INDUSTRIA
• AUTOMOTIVE
• TRASPORTI


MECCANICA E
AUTOMAZIONE
MICROMECCANICA
INDUSTRIA
CERAMICA VETRO
GOMME
POLIURETANICHE
ADESIVE
PARACOLPI
NANO
TECNOLOGIE
NANO RIPORTI
POLIETILENE A
ULTRA PESO
MOLECOLARE
ADESIVO
BI ADESIVI
ACRILICI
VISCOELASTICI
• COSTRUTTORI DI MACCHINE
• PROTEZIONI
• AUTOMOTIVE
• INDUSTRIA

•ARREDAMENTO
•INDUSTRIA
•ALIMENTARE
•TRASPORTI
•ELETTRONICA

•INDUSTRIA
•AUTOMOTIVE
•MACCHINE

MS POLIMERI
ECO POLIURETANI SILICONI
GOMME ED ESPANSI
PREFORMATI BITILICI
•AUTOMOTIVE
•STAMPAGGIO CARBONIO
•LAMIERE

•ALLESTIMENTO VEICOLI


BIADESIVI
ACRILICI VISCOELASTICI

•INDUSTRIA
•ARREDAMENTO
•AUTOMOTIVE
•TRASPORTI




MS POLIMER è un adesivo sigillante monocomponente a rapida polimerizzazione altamente e permanentemente elastico ed elevata coesione. MS POLIMER viene utilizzato per realizzare sigillature e giunzioni adesive elastiche di elevate prestazioni.
Queste le principali caratteristiche di MS POLIMER: - Ottima adesione su una ampia varietà di superfici. MS POLIMER può essere applicato con semplici pretrattamenti su differenti substrati (alluminio, alluminio anodizzato, GRP poliestere e acciaio inox): ottima adesione senza primer su molti metalli non verniciati e su legni duri quali mogano e tek (talvolta può essere consigliabile una semplice pulizia a tampone, ottima adesione anche su vecchio silicone o poliuretano (si consigliano in ogni caso prove preliminari);
-Verniciabile (catena polimerica non siliconica) immediatamente dopo il fuori polvere umido su umido con la maggior parte delle vernici industriali senza influenzare i tempi di indurimento;
- Verniciabile con vernici a forno. I cicli di cottura di durata variabile tra 20 - 60 minuti alle temperature di 60 - 120°C o anche 180 -200°C per quelle a polvere, non danneggiano o modificano il sigillante. In qualche caso è possibile anche verniciare umido su umido e cuocere in forno immediatamente;
- Indurimento rapido per reazione con l'umidità dell'aria (reazione neutra);
- Esente da isocianati e solventi;
- Non sviluppa gas durante l'indurimento, non presenta bolle e rigonfiamenti;
- Buona estrudibilità alle diverse temperature;
-Migliore resistenza a carichi dinamici ciclici (numero cicli fatica/vibrazioni sino a rottura) rispetto ad altri sistemi mono componenti;
- Ottima resistenza a raggi U.V., sostanze acide, alcaline, solventi ed acqua marina.









•INDUSTRIA ALIMENTARE
•INDUSTRIA MEDICALE
•AUTOMOTIVE


•INDUSTRIA ALIMENTARE
•INDUSTRIA MECCANICA
•MACCHINE AUTOMATICHE



•MACCHINARI
•SCAFFALATURE
•CONTENITORI METALLICI
SUPERFICI VERNICIATE A POLVERE
•INDUSTRIA ALIMENTARE
•AEROSPAZIALE
•TRASPORTI




E’ buona norma, prima di effettuare un incollaggio, e, dopo aver scelto accuratamente il prodotto giusto, dedicare attenzione alla preparazione superfici.
1. Eliminare ogni contaminazione superficiale sgrassaggio
• Sgrassaggio con vapori di trielina
• Sgrassaggio Alcalino
• Decapaggio Acido (acido fosforico) o Alcalino
2. Pulitura con solventi (Alcol, MEK, Eptano)
3. Trattamenti superficiali


• Abrasione. In al modo si otterrà maggior superficie di contatto, rimozione di eventuali sostanze distaccanti e maggior unità superficiale. Grana 100/120 per la verniciatura a polvere.
4. TEST : Snap Tape – Water Break
• Snap tape prova di strappo per verificare se la superficie è molto sporca o per verificare se i substrati tipo vernici sono ben ancorati.
• Water Break prova per verificare la presenza di oli, grassi o siliconi sulle superfici. Si versa una piccola quantità d’acqua deve scivolare senza formare goccioline.
Di seguito troverete alcuni consigli per valutare alcuni materiali nel migliore dei modi.
Tipo di materiale
Materie plastiche in generale
Suggerimenti
Prestare attenzione ai distaccanti usati durante lo stampaggio creano di molte difficoltà. Meglio informare il fornitore di materie plastiche che si incollare il materiale acquistato. Si consiglia, se possibile una leggera passata con abrasivo fine tipo Scotch Brite, e pulitore sgrassante. (alcol isopropilico) PP - PPL
VINILI PLASTIFICATI (PVC)
POLICARBONATO (Lexan®, Macrolon®, ecc. ecc.) e vetroresine

Tutti i materiali LSE (low surface energy) devono essere incollati con particolare cautela. In questi casi oltre alla normale procedura generale si consiglia la pulizia con acetone e l’utilizzo di un PRIMER per poliolefine, nonché l’utilizzo di prodotti specifici. Da segnalare trattamenti alla fiamma e trattamenti corona.
Per questo tipo di materiali l’unico nemico è la presenza di plastificanti. (Si può riconoscere la presenza di queste sostanze in base alla loro flessibilità o plasticità)
Più sono flessibili e morbidi e maggiormente sono da trattare con cautela. In questo caso si suggeriscono le normali operazioni di pulizia e l’utilizzo di prodotti specifici.
Valgono le normali regole di pulizia. Si segnala, l’eventualità di emissioni gassose (outgassing). SI consiglia di verificarne la presenza applicando nastro mono adesivo,

e verificare nel tempo la formazione di bollicine. Si possono accelerare i risultati in forno per qualche ora.
ACRILATI (Pexiglass®), ABS Classiche regole di pulizia e dove è possibile leggera abrasione.
Gomme (Nbr, Sbr) (CR, EPDM) (Uretani)
Gomme siliconiche
Le gomme sono ritenute materiali critici, in parte per caratteristiche LSE (EPDM e CR) ed in parte per la presenza di distaccanti e talchi protettivi. Sono da trattare con particolare attenzione effettuando pulizia, sgrassaggio, abrasione e applicando, prima dell’incollaggio, primer idonei
Le gomme siliconiche necessitano di prodotti dedicati con adesivi siliconici. Ovvie le normali norme di pulizia,I risultati non sono mai eclatanti ma si possono notevolmente migliorare utilizzando preparatori superficiali specifici.
Materiali silicei (Vetro –Ceramica )
Metalli (Alluminio – Ottone –
Rame –
ZincoAcciaio)
Verniciatura a polvere
L’unico neo di questo materiale è igroscopicità. Deve essere ben pulito e trattato con primer silanici per ottenere il massimo delle prestazioni
Per la maggior parte dei metalli il pericolo maggiore l’ossidazione. Valgono le regole base dei pulizia sgrassaggio con particolare attenzione all’abrasione all’utilizzo di pulitori che non lascino residui. Un buon pulitore aggressivo è il MEK . Per l’ossido di zinco è efficace l’abrasione additivata di acido fosforico 6/8%


Aspetto critico da non sottovalutare. Da trattare con primer e prodotti specifici. Se possibile, l’abrasione asporta la patina superficiale lucida,principale causa di distacchi.
Anche l’acetone di solito si rivela sufficientemente aggressivo da promuovere l’adesione.




•MECCANICA
•ARREDAMENTO
•ASSEMBLATI
TRAZIONE
PELATURA
DINAMOMETRICA
INVECCHIAMENTO
ACCELLERATO
•ELETTRONICA
•INDUSTRIA

RESISTENZA
TERMICA
RESISTENZA
AL GELO
•FORNI
•FRIGORIFERI
•AUTOMOTIVE
SHOCK TERMICO
TRASPARENZA
•EPOSITORI DUREVOLI
•PRODOTTI PER ESTERNO


• ELETTRONICA
• CARTOTECNICA
• INDUSTRIA
• AUTOMOTIVE

DOSATORI
VOLUMETRICI ADESIVI IN PASTA
FORNI , FUSORI E SISTEMI UV CURE
• INDUSTRIA
• CARTOTECNICA
• OGGETTISTICA
• GADGETS

ROBOT CARTESIANI
MAGAZZINO CARICO/SCARICO
• INDUSTRIA

AUTOMOTIVE
ELETTRONICA
ELETTRODOMESTICI
DISPENSER E
APPLICATORI
NASTRI ADESIVI


• CARTOTECNICA
• AUTOMOTIVE
• ELETTRODOMESTICI






Bond Srl Via Giambi 45c 41017 Ravarino fraz.Rami Modena Italia www.bondsrl.net Tel. +39 (0)59 905154 info@bondsrl.net

Etica professionale e consapevolezza Professionisti che lavorano in squadra

1. Innovazione tecnologica
2. Competenza e professionalità
3. Consulenza globale
4. Contesto internazionale
5. Disponibilità
6. Soluzioni mirate
Direzione: dir@bondsrl.net
Direzione Tecnica: areatecnica@bondsrl.net
Amministrazione: amministrazione@bondsrl.net
Servizio Clienti: customercare@bondsrl.net
Sistema Qualità: areaqualita@bondsrl.net



Cordialità e rispetto


Scegliere BOND significa essere attenti al cambiamento !!!!